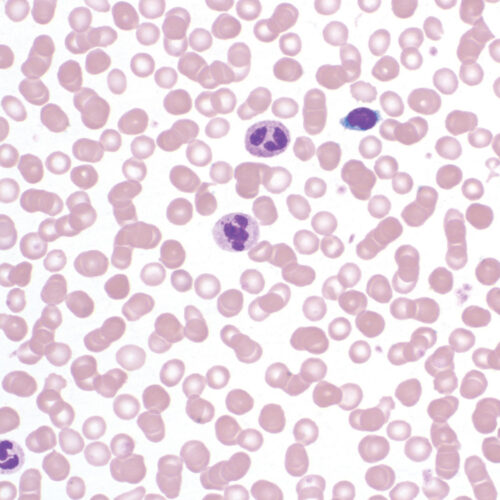

Citology and hematology staining reagents
-
Histology and cytology/Citology and hematology staining reagents/Rapid and standard hematology reagents and kits/Bio-Diff kits/BioGnost Bio-Diff Kit
Bio-Diff 1 reagent
Fixative agent, component of Bio-Diff kit.
-
Histology and cytology/Citology and hematology staining reagents/Rapid and standard hematology reagents and kits/Bio-Diff kits
Bio-Diff 1 RTU reagent
Fixative component Bio-Diff RTU kit.
-
Histology and cytology/Citology and hematology staining reagents/Rapid and standard hematology reagents and kits/Bio-Diff kits
Bio-Diff 2 RTU reagent
Red component of Bio-Diff RTU kit.
-
Histology and cytology/Citology and hematology staining reagents/Rapid and standard hematology reagents and kits/Bio-Diff kits
Bio-Diff 3 RTU reagent
Blue component of Bio-Diff RTU kit.
-
Histology and cytology/Citology and hematology staining reagents/Rapid and standard hematology reagents and kits/Bio-Diff kits/BioGnost Bio-Diff Kit
Bio-Diff kit
Three-reagent kit that contains fi xative agent, red and blue components for fast and effective staining. Each kit contains buffer tablets for consistent staining results.
-
Histology and cytology/Citology and hematology staining reagents/Rapid and standard hematology reagents and kits/Bio-Diff kits
Bio-Diff RTU kit
Ready-to-Use three-reagent kit with reagents stored in containers that can be used as staining jars. Kit contains fixative agent, red and blue components for fast and effective staining and buffer tablet for consistent staining results.